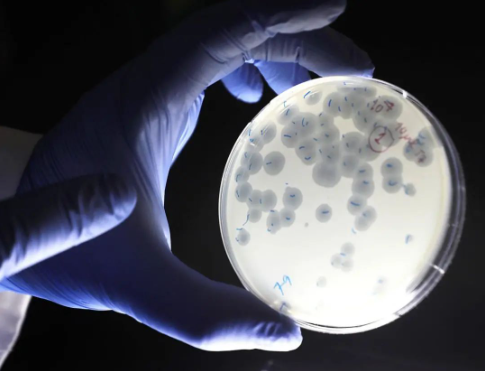

向结核进军——Graham Hatfull和他的噬菌体王国
2022年5月,Graham Hatfull教授团队与合作者们接连在Nature Communications和Cell杂志发表的2篇噬菌体治疗论文被广泛报道。这并非Hatfull团队第一次“出圈”,2019年和2021年,该团队两度在Nature Medicine杂志发表噬菌体治疗论文,尤其是2019年报道的全球首例基因编辑噬菌体治疗案例曾轰动一时。Hatfull教授在噬菌体基因组学研究领域耕耘30多年,其创办的“噬菌体猎手”教育研究项目(SEA-PHAGES)在20年间积累了将近2万株规模的分枝杆菌噬菌体库。噬菌体基因组学研究、SEA-PHAGES资源积累和临床治疗研究组成了Hatfull噬菌体王国的“三军”,正在向包括结核分枝杆菌在内的古老病种发起挑战。